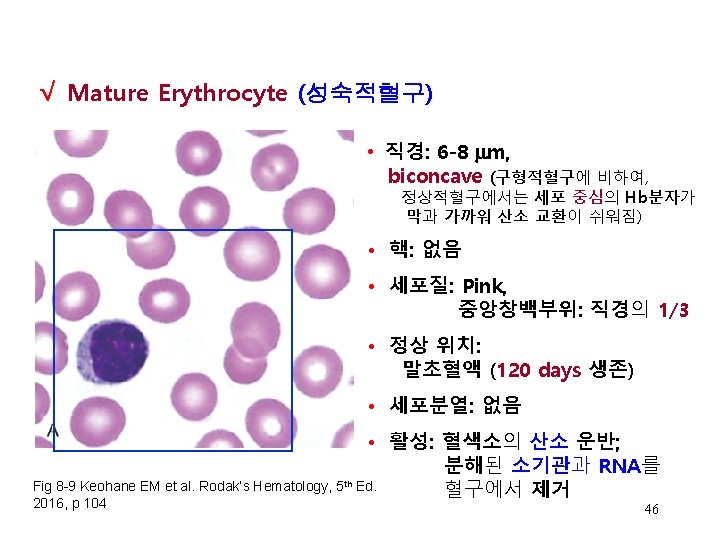

Lecture 2 HEMATOPOIESIS RBC PRODUCTION DESTRUCTION Chapter 7

Lecture 2 HEMATOPOIESIS; RBC PRODUCTION & DESTRUCTION Chapter 7, 8 Chapter Author: Kathryn Doig, Ph. D March 15, 2019 Elaine M. Keohane, Ph. D, MLS(ASCP)SH keohanem@shrp. rutgers. edu Rutgers-The State University of New Jersey School of Health Related Professions and Kyung Jin Cho, Ph. D, Professor Emeritus chokj@korea. ac. kr Dept. of Medical Laboratory Science College of Health Sciences, Korea University



Hematopoiesis – Cont’d • 조혈체계 √ 조혈기관 • • • Bone Marrow Liver Spleen Lymph nodes Thymus 4

Hematopoiesis – Cont’d • 조혈체계 √태아기조혈의 세 국면 Hypoblast 1) 중배엽기(mesoblastic phase) YS - 수태 후 16일: 중배엽의 세포가 배아(2 -8주 후)밖 (extraembryonic) 난황으로 이동 후, √ 수태 후 19일: blood island형성: 원시적혈모세포가 원시적, 일시적 조혈을 시작. 이 때의 조혈은 빠르게 발달 중인 배아조직에 산소를 운반하기 위한 primitive erythroblast, MØ만 나타남 혈색소: Gower-1, Gower -2, Portland형 Hb형성 - 수태 후 27일: AGM*으로 이동 한 중배엽세포들이 HSC형성하고, √결정적 조혈 (myeloid, lymphoid 계열 모두 조혈) *: AGM, aorta-gonad-mesonephros (대동맥-생식융기-중신) Flk 1, CD 34, Mix, AML 1 Hem (pro atopo i from genito etic an hem r) cel d vas cula ang ls fo r r iob last matio stem n ** Baron MH, J Hematotherapy & Stem Cell Research 10, 587 -594


Hematopoietic Organs √ Fig 7 -1 Keohane EM et al. , Hematology-Clinical Principles and Applications, Elsevier, 2016, p 71 7







Osteoblastic vs Vascular Niche “quiescent” . “transendothelial migration, mobilization, homing” Yin T & Li L, JCI 2006; 116: 1195. 14


Extracellular Matrix (ECM, 세포외기질) HSC들의 바탕질(matrix)에 점착을 촉진하는 단백성분 세포외기질을 구성하는 주요 단백과 당단백: – – – Collagen Fibronectin Laminin Hemonectin Thrombospondin 16






√ Stem Cell Theory – Common Myeloid Progenitor Cell (CMP) Granulocyte. Monocyte Progenitor Eosinophil. Basophil Progenitor 단일계통 발생설 Multipotent Hematopoietic Stem Cell (HSC) Megakaryocyte. Erythrocyte Progenitor Common Lymphoid Progenitor Cell (CLP) T Progenitor B Progenitor Dendritic cell Neut Mono Eos Purple = HSC Red = progenitor cell Blue = mature cell Baso Erythrocytes Mast Cell Platele ts T Lymph NK cell B Lymph See Rodak, 2016, Fig 7 -13, p 86 22

Hematopoiesis – Cells Derived from HSC Rodak, 2016, Fig 7 -13 23 Elsevier items and derived items © 2012, 2007, 2003 by Saunders, an imprint of Elsevier Inc. , Page 86


HSC의 운명 Ø Self-renewal Ø Differentiation Ø Apoptosis HSC는 비대칭 분열 (Asymmetrical Division) 딸 세포 하나는 특정 혈구세포 계열로 분화 (Differentiation) 또 다른 딸세포는 줄기세포특성 을 유지함 (self renewal) Ref: NJ Drize et al, Blood 88, 2927 (1996) 25

√ Cytokines Ø 조혈 전구세포의 분화, 증식, 성숙을 조절 조혈촉진: Kit-L, Flt 3 -L, GM-CSF, IL-1, 3, 6, 11 조혈조절: TGF-β, TNF-α, interferon Ø Ø 전구세포와 성숙세포에서의 신호 조절 특정 인자의 활성화 또는 억제 기능 Interleukins (ILs)는 cytokine의 종류 성장인자(GFs): 전구세포 성장과 생존 촉진 [Cytokine의 예] Ø Ø Ø Ø Colony stimulating factors (CSFs) Erythropoietin (EPO) Thrombopoietin (TPO) 다양한 IL-series Interferon Lymphokine Chemokines 26

√ Effect of Cytokines on Hematopoiesis Kit-L (SCF), Flt 3 -L √ Kit-L(SCF), Flt 3 -L GM-CSF, IL-1, 3, 6, 11 Common Myeloid Progenitor Cell (CMP) FLT 3 L, SCF, GM-CSF G-CSF Multipotent Hematopoietic Stem Cell (HSC) Common Lymphoid Progenitor Cell (CLP) FLT 3 L SCF FLT 3 L, SCF, GM-CSF IL-3 √ IL-3, 5 √ IL-3 Granulocyte. Monocyte Progenitor √ IL-7 Eosinophil. Basophil Progenitor Megakaryocyte. Erythrocyte Progenitor FLT 3 L, IL-7 T Progenitor FLT 3 L, IL-7 B Progenitor M-CSF Mast Cell Neut Mono Eos Baso EPO TPO Platele ts Erythrocytes Dendritic cell FLT 3 L=FMS-like tyroine kinase 3 ligand SCF=stem cell factor GM-CSF=granulocyte-monocyte colony-stimulating factor G-CSF=granulocyte colony-stimulating factor M-CSF=monocyte colony-stimulating factor IL=interleukin EPO=erythropoietin TPO=thrombopoietin T Lymph NK cell B Lymph See Rodak, 2016, Fig 7 -15 p. 88 27

Erythropoiesis(적혈구조혈) 적혈구 조혈은 • 혈구생성 • 혈구성숙 • 혈구파괴 사이에서 일정한 균형 유지 • 적혈구계의 기능적감별가능한 BFU-E(적은 수의 EPO수용체 보유)에서 CFU-E(많은 수의 EPO수용체보유)로 성숙에 1 주; CFU-E에서 다시 형태학적 감별가능한 Pronormoblast 까지 1주; Pronomoblast에서 RBC 까지 1주; 즉, BFU-E에서 mature RBCs 까지 약 3주, 총 18 -21일 소요 BFU-E CFU-E https: //www. rndsystems. com/resources/protocols/human-colony-forming-cell-cfc-assay-using-methylcellulose-based-media 28


ERYTHROCYTE PRODUCTION AND DESTRUCTION Chapter 8 Chapter Author: Kathryn Doig, Ph. D 30

Erythrocyte Production (적혈구 생성): 복제/성숙 BFU-E에서 CFU-E 까지: 일주일 CFU-E에서 Pronormo B까지: 일주일 Pronormobl에서 RBC까지: 일주일 총 18 -21일 1 Pronormoblast normally 3 Divisions 7 days Fig 8 -1 Rodak혈액학 범문에듀케이션, 5 th Ed, 2019, p 99 Fig 8 -1 Rodak혈액학 5 th Ed. , 2019 범문에듀케이션, p 99 Normally 8 Adult RBCs

Nomenclature Younger Immature Older Mature Normoblastic Rubriblastic Erythroblastic (미국에서) (백혈구발달처럼) (유럽에서) √ Pronormoblast Rubriblast Proerythroblast Basophilic Normoblast Prorubricyte Basophilic Erythroblast Polychromatic Normoblast Rubricyte Polychromic Erythroblast Orthochromic Normoblast Metarubricyte Orthochromic Erythroblast Polychromatic Erythrocyte* Polychromatic erythrocyte Erythrocyte From: Doig K. In Rodak, Fritsma, , Keohane: Hematology, Clinical Principles and Applications, 4 th ed. 2012, p. 87 Pronormoblast: 형태학적 감별 가능한 적혈구계 최초의 미성숙세포 *: Polychromatic erythrocyte ⇒ Reticulocyte 32

혈구 감별 기준 Older Younger - √핵 염색질 패턴 - 핵의 크기 (직경) - 핵소체 존재 여부 Smooth Open Chromatin Condensed Coarse Chromatin Pyknotic Chromatin - 핵/세포질의 비 (N: C ratio, N/C ratio) - 세포질 색상 N: C Ratio 33


RBC Maturation Sequence Bone Marrow Pronormoblast (Rubriblast) 전 적혈모세포 Basophilic normoblast (Prorubricyte) 호염기 적혈모세포 (부염색질 나타남) √ Polychromatic normoblast (Rubricyte) 다염 적혈모세포 (√ 뚜렷한 부염색질-적혈구계 세포의 특징) Peripheral blood Orthochromic normoblast (Metarubricyte) 정염적혈모세포 √Polychromatic erythrocyte; reticulocyte(초생체염색 시) 다염적혈구 Erythrocyte 적혈구 35 Image From: Diggs LW, Sturm D, Bell A: The Morphology of Human Blood Cells, 5 th ed. Abbott Park, IL, Abbott Laboratories, 1985. p. 26

Pronormoblast (Rubriblast, 전적혈모세포) • 직경: 12 -20 m • 핵: high N: C ratio, smooth, open chromatin, 1 -2 핵소체 • 세포질: Dark blue • 정상 위치: bone marrow • 세포분열: 일어남 • 활성: √철흡수 및 Protoporphyrin 합성 위한 단백질 합성; Globin 사슬합성 개시 Fig 8 -4 A Keohane EM et al. Hematology-Clinical Principles and Applications, Elsevier, 2016, p 100 • 성숙단계시간: 24 hrs 36

Basophilic Normoblast (Prorubricyte, 호염기적혈모세포) • 직경: 10 -15 m • 핵: lower N: C ratio, 약간 농축된 염색질, 0 -1 nucleoli, parachromatin*나타남 • 세포질: Dark blue • 정상 위치: BM • 세포분열: 일어남 • 활성: 약간의 Hb 합성 이루어지지만, 리보좀과 RNA에 가려져 혈색소는 거의 안 보임 Fig 8 -5 A Keohane EM et al. Hematology-Clinical Principles and Applications, Elsevier, 2016, p 100 • 성숙단계 시간: 24 hrs *: parachromatin – 핵내 염색되지 않은 하얀 부위 37

Pronormoblast vs Basophilic Normoblast Fig 8 -4 A and 8 -5 A Keohane EM et al. Hematology-Clinical Principles and Applications, Elsevier, 2016, p 100 Copyright © 2012, 2007, 2002, 1995 by Saunders, an imprint of Elsevier Inc. 38

Polychromatic Normoblast (Rubricyte, 다염적혈모세포 ) • 직경: 10 -12 m • 핵: lower N: C ratio, 농축된 염색질, 핵소체 없음(더 이상 전사 못함) √ 뚜렷한 parachromatin • 세포질: √ Blue-pink, grayish • 정상 위치: BM • 유사분열: 일어남 (√마지막 단계) • 활성: Hb 합성으로 세포질 내 pinkish color 나타나며, DNA 전사는 중단 Fig 8 -6 A Keohane EM et al. Hematology-Clinical Principles and Applications, Elsevier, 2016, p 101 • 성숙단계 시간: 30 hrs parachromatin – white unstained areas in nucleus 39

Basophilic Normoblast vs Polychromatic Normoblast Fig 8 -5 A and 8 -6 A Keohane EM et al. Hematology-Clinical Principles and Applications, Elsevier, 2016, p 100 -101 Copyright © 2012, 2007, 2002, 1995 by Saunders, an imprint of Elsevier Inc. 40


Polychromatic Normoblast vs Orthochromic Normoblast Fig 8 -6 A and 8 -7 A Keohane EM et al. Hematology-Clinical Principles and Applications, Elsevier, 2016, p 101 Copyright © 2012, 2007, 2002, 1995 by Saunders, an imprint of Elsevier Inc. 42


Reticulocytes (그물적혈구) in √ Super vital stain Fig 8 -8 B Rodak혈액학 5 th 범문에듀케이션, 2019, p 104 44 Fig 8 -9 Keohane EM et al. Rodak’s Hematology, 5 th Ed. 2016, p 103

Orthochromic Normoblast vs Polychromatic Erythrocyte Fig 8 -7 A and 8 -8 A Keohane EM et al. Hematology-Clinical Principles and Applications, Elsevier, 2016, p 101 -102 Copyright © 2012, 2007, 2002, 1995 by Saunders, an imprint of Elsevier Inc. 45

Polychromatic Erythrocyte vs Mature Erythrocyte Spleen Splenic MØ membrane polishing 47 Fig 8 -8 A-B 8 -10 A-B Keohane EM. Hematology-Clinical Principles and Applications, Elsevier, 2016, p 102 -103.

Nucleated RBCs (n. RBCs, 유핵적혈구) Pronormoblast Basophilic Normoblast √ Polychromatic Normoblast Orthochromic Normoblast Fig 8 -4 A, 8 -5 A, 8 -6 A, 8 -7 A Rodak BF, Fritsma GA, Keohane EM. Hematology-Clinical Principles and Applications, Elsevier, 2012, p 91 -93. Copyright © 2012, 2007, 2002, 1995 by Saunders, an imprint of Elsevier Inc. 48





Erythropoietin (EPO) 작용 개요 More RBCs in Circulation Hb 감소 , RBCs 감소 Hypoxia – 조직내 낮은 O 2 분압 BM 조기방출 허용: RBC막 수용체발현 , PB내 shift reticulocytes와 n. RBCs 출현 세포자멸사 회피: Bcl-x. L 발현증가; Fas. L생성 감소, Fas전구세포 증가 세포성숙기간 단축* (true shift retics: 6일에서 4일로) *: 세포주기 짧아 짐 Erythropoietin BM Kidney RBC Precursor √ Shift reticulocytes 는 younger retics 로 순환혈액으로 유입된 후, mature RBC로 성숙하는데 더 오래 걸림 (48 -72 hrs) * Polychromasia on blood smear

적혈구조혈에 참여하는 기타 hormones √ Testosterone (androgens) (m-Hb > f-Hb) • 뇌하수체 hormones • 갑상선 hormones 54


Erythrocyte Destruction • √ 120일 지난 RBCs들은 수명 다한 노쇠한 적혈구 됨 Ø Ø Cation balance유지(Na pump) 능력 감소 적혈구막 변화 √ 적혈구는 nucleus, ribosomes, mitochondria 없어 단백질(효소)합성 불가 필수효소 소실(ATP생성↓) Ø 적혈구막 소실 (표면적↓ √ spherocytes ) • 노쇠적혈구 파괴: 두 가지 과정 ~ √ 90% extravascular hemolysis (in spleen) ~ 10% intravascular hemolysis (in circulation) • • due to mechanical or traumatic stress cell contents released in plasma 56

√ Extravascular Hemolysis (혈관외 용혈) • 비장 적색속질: RBCs들 glucose, p. H, oxidants에 노출 • Senescent RBCs은 spherocytes로 변형 • 구형 RBCs 비장에 갇힘 √ MØs’ phagocytosis Fig 8 -12 Rodak BF, Fritsma GA, Keohane EM. Hematology-Clinical Principles and Applications, Elsevier, 2012, p 99. Copyright © 2012, 2007, 2002, 1995 by Saunders, an imprint of Elsevier Inc. Macrophage ingesting a spherocytic RBC 57

√ Hemoglobin Degradation (혈색소 분해) Intravascular Hemolysis Extravascular Hemolysis (mechanicall fragmentation) Hb released from RBC in circulation, binds with √haptoglobin, transported to liver Senescent RBC phagocytized in spleen (Mø) Hemoglobin Iron Reused Polypeptide Reused Protoporphyrin ring Bilirubin (unconjugated) Liver Bilirubin (conjugated) Intestines Urobilinogen (excreted in feces and urine) 58
- Slides: 58